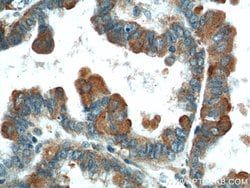
Img

50-558-074
IFT20 Rabbit anti-Canine, Human, Mouse, Polyclonal, Proteintech
Manufacturer: Proteintech Group Inc
Select a Size
| Pack Size | SKU | Availability | Price |
|---|---|---|---|
| Each of 1 | 50-558-074-Each-of-1 | In Stock | ₹ 44,150.23 |
50-558-074 - Each of 1
In Stock
Quantity
1
Base Price: ₹ 44,150.23
GST (18%): ₹ 7,947.041
Total Price: ₹ 52,097.271
Antigen
IFT20
Classification
Polyclonal
Conjugate
Unconjugated
Gene
IFT20
Gene Alias
hIFT20, IFT20
Host Species
Rabbit
Purification Method
Antigen Affinity Chromatography
Regulatory Status
RUO
Gene ID (Entrez)
480620, 55978, 90410
Content And Storage
-20°C
Form
Liquid
Applications
Immunocytochemistry, Immunofluorescence, Immunohistochemistry (Paraffin), Immunoprecipitation, Western Blot
Concentration
0.22 mg/mL
Formulation
PBS with 50% glycerol and 0.02% sodium azide; pH 7.3
Gene Accession No.
Q61025, Q8IY31
Gene Symbols
IFT20
Immunogen
IFT20 Fusion Protein Ag4521
Quantity
150 μL
Primary or Secondary
Primary
Target Species
Canine, Human, Mouse
Product Type
Antibody
Isotype
IgG
Description
- IFT20 is part of intraflagellar transport (IFT) particles involved in ciliary process assembly
- IFT20 may play a role in the trafficking of ciliary membrane proteins from the Golgi complex to the cilium.
Compare Similar Items
Show Difference
Antigen: IFT20
Classification: Polyclonal
Conjugate: Unconjugated
Gene: IFT20
Gene Alias: hIFT20, IFT20
Host Species: Rabbit
Purification Method: Antigen Affinity Chromatography
Regulatory Status: RUO
Gene ID (Entrez): 480620, 55978, 90410
Content And Storage: -20°C
Form: Liquid
Applications: Immunocytochemistry, Immunofluorescence, Immunohistochemistry (Paraffin), Immunoprecipitation, Western Blot
Concentration: 0.22 mg/mL
Formulation: PBS with 50% glycerol and 0.02% sodium azide; pH 7.3
Gene Accession No.: Q61025, Q8IY31
Gene Symbols: IFT20
Immunogen: IFT20 Fusion Protein Ag4521
Quantity: 150 μL
Primary or Secondary: Primary
Target Species: Canine, Human, Mouse
Product Type: Antibody
Isotype: IgG
Antigen:
IFT20
Classification:
Polyclonal
Conjugate:
Unconjugated
Gene:
IFT20
Gene Alias:
hIFT20, IFT20
Host Species:
Rabbit
Purification Method:
Antigen Affinity Chromatography
Regulatory Status:
RUO
Gene ID (Entrez):
480620, 55978, 90410
Content And Storage:
-20°C
Form:
Liquid
Applications:
Immunocytochemistry, Immunofluorescence, Immunohistochemistry (Paraffin), Immunoprecipitation, Western Blot
Concentration:
0.22 mg/mL
Formulation:
PBS with 50% glycerol and 0.02% sodium azide; pH 7.3
Gene Accession No.:
Q61025, Q8IY31
Gene Symbols:
IFT20
Immunogen:
IFT20 Fusion Protein Ag4521
Quantity:
150 μL
Primary or Secondary:
Primary
Target Species:
Canine, Human, Mouse
Product Type:
Antibody
Isotype:
IgG
Antigen: VTCN1
Classification: Polyclonal
Conjugate: Unconjugated
Gene: VTCN1
Gene Alias: B7 H4, B7h.5, B7H4, B7S1, B7X, PRO1291, Protein B7S1, RP11 229A19.4, VCTN1, VTCN1
Host Species: Rabbit
Purification Method: Antigen Affinity Chromatography
Regulatory Status: RUO
Gene ID (Entrez): 242122, 295322, 79679
Content And Storage: -20°C
Form: Liquid
Applications: Immunohistochemistry (Paraffin), Western Blot
Concentration: 0.23 mg/mL
Formulation: PBS with 50% glycerol and 0.1% sodium azide; pH 7.3
Gene Accession No.: Q501W4, Q7TSP5, Q7Z7D3
Gene Symbols: VTCN1
Immunogen: VTCN1 Fusion Protein Ag2712
Quantity: 150 μL
Primary or Secondary: Primary
Target Species: Human, Mouse, Rat
Product Type: Antibody
Isotype: IgG
Antigen:
VTCN1
Classification:
Polyclonal
Conjugate:
Unconjugated
Gene:
VTCN1
Gene Alias:
B7 H4, B7h.5, B7H4, B7S1, B7X, PRO1291, Protein B7S1, RP11 229A19.4, VCTN1, VTCN1
Host Species:
Rabbit
Purification Method:
Antigen Affinity Chromatography
Regulatory Status:
RUO
Gene ID (Entrez):
242122, 295322, 79679
Content And Storage:
-20°C
Form:
Liquid
Applications:
Immunohistochemistry (Paraffin), Western Blot
Concentration:
0.23 mg/mL
Formulation:
PBS with 50% glycerol and 0.1% sodium azide; pH 7.3
Gene Accession No.:
Q501W4, Q7TSP5, Q7Z7D3
Gene Symbols:
VTCN1
Immunogen:
VTCN1 Fusion Protein Ag2712
Quantity:
150 μL
Primary or Secondary:
Primary
Target Species:
Human, Mouse, Rat
Product Type:
Antibody
Isotype:
IgG
Antigen: ABHD5
Classification: Polyclonal
Conjugate: Unconjugated
Gene: ABHD5
Gene Alias: ABHD5, CDS, CGI58, IECN2, NCIE2
Host Species: Rabbit
Purification Method: Antigen Affinity Chromatography
Regulatory Status: RUO
Gene ID (Entrez): 51099, 67469
Content And Storage: -20°C
Form: Liquid
Applications: Immunocytochemistry, Immunofluorescence, Immunohistochemistry (Paraffin), Immunoprecipitation, Western Blot
Concentration: 0.25 mg/mL
Formulation: PBS with 50% glycerol and 0.1% sodium azide; pH 7.3
Gene Accession No.: Q8WTS1, Q9DBL9
Gene Symbols: ABHD5
Immunogen: ABHD5 Fusion Protein Ag2840
Quantity: 150 μL
Primary or Secondary: Primary
Target Species: Human, Mouse
Product Type: Antibody
Isotype: IgG
Antigen:
ABHD5
Classification:
Polyclonal
Conjugate:
Unconjugated
Gene:
ABHD5
Gene Alias:
ABHD5, CDS, CGI58, IECN2, NCIE2
Host Species:
Rabbit
Purification Method:
Antigen Affinity Chromatography
Regulatory Status:
RUO
Gene ID (Entrez):
51099, 67469
Content And Storage:
-20°C
Form:
Liquid
Applications:
Immunocytochemistry, Immunofluorescence, Immunohistochemistry (Paraffin), Immunoprecipitation, Western Blot
Concentration:
0.25 mg/mL
Formulation:
PBS with 50% glycerol and 0.1% sodium azide; pH 7.3
Gene Accession No.:
Q8WTS1, Q9DBL9
Gene Symbols:
ABHD5
Immunogen:
ABHD5 Fusion Protein Ag2840
Quantity:
150 μL
Primary or Secondary:
Primary
Target Species:
Human, Mouse
Product Type:
Antibody
Isotype:
IgG
Antigen: EPCAM
Classification: Polyclonal
Conjugate: Unconjugated
Gene: EPCAM
Gene Alias: CD326, CO 17A, CO17 1A, EGP, EGP 2, EGP314, EGP34, EGP40, Ep CAM, EPCAM, Epithelial glycoprotein, Epithelial glycoprotein 314, ESA, GA733 2, hEGP 2, hEGP314, KS 1/4 antigen, KS1/4, KSA, M1S2, M4S1, MIC18, MK 1, TACST 1, TACSTD1, TROP1
Host Species: Rabbit
Purification Method: Antigen Affinity Chromatography
Regulatory Status: RUO
Gene ID (Entrez): 17075, 4072
Content And Storage: -20°C
Form: Liquid
Applications: Immunocytochemistry, Immunofluorescence, Immunohistochemistry (Paraffin), Western Blot
Concentration: 0.29 mg/mL
Formulation: PBS with 50% glycerol and 0.02% sodium azide; pH 7.3
Gene Accession No.: P16422, Q99JW5
Gene Symbols: EPCAM
Immunogen: EPCAM Fusion Protein Ag15393
Quantity: 150 μL
Primary or Secondary: Primary
Target Species: Human, Mouse
Product Type: Antibody
Isotype: IgG
Antigen:
EPCAM
Classification:
Polyclonal
Conjugate:
Unconjugated
Gene:
EPCAM
Gene Alias:
CD326, CO 17A, CO17 1A, EGP, EGP 2, EGP314, EGP34, EGP40, Ep CAM, EPCAM, Epithelial glycoprotein, Epithelial glycoprotein 314, ESA, GA733 2, hEGP 2, hEGP314, KS 1/4 antigen, KS1/4, KSA, M1S2, M4S1, MIC18, MK 1, TACST 1, TACSTD1, TROP1
Host Species:
Rabbit
Purification Method:
Antigen Affinity Chromatography
Regulatory Status:
RUO
Gene ID (Entrez):
17075, 4072
Content And Storage:
-20°C
Form:
Liquid
Applications:
Immunocytochemistry, Immunofluorescence, Immunohistochemistry (Paraffin), Western Blot
Concentration:
0.29 mg/mL
Formulation:
PBS with 50% glycerol and 0.02% sodium azide; pH 7.3
Gene Accession No.:
P16422, Q99JW5
Gene Symbols:
EPCAM
Immunogen:
EPCAM Fusion Protein Ag15393
Quantity:
150 μL
Primary or Secondary:
Primary
Target Species:
Human, Mouse
Product Type:
Antibody
Isotype:
IgG